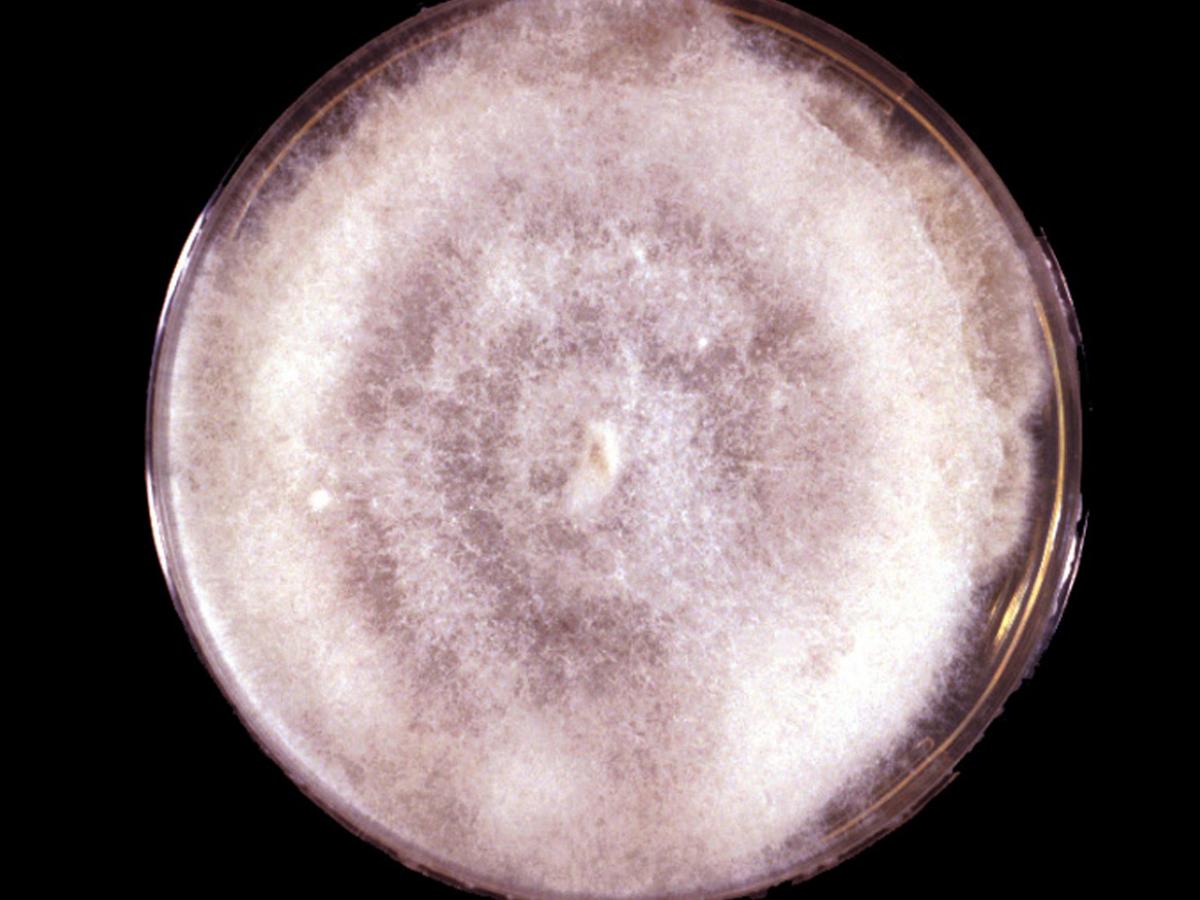
Culture

Status message
Correct! Excellent, you have really done well. Please find additional information below.
Unknown 40 = Apophysomyces elegans
Clinical presentation: The blistering on the medial aspect of the right foot was the first sign of infection.

Direct microscopy: Tissue morphology in zygomycosis showing distinctive infrequently septate thin walled hyphae with focal bulbous dilations and irregular branching, typical for those species belonging to the Mucorales.

Culture: Colonies are fast growing, white becoming creamy white to buff with age, downy with no reverse pigment, and are composed of broad, sparsely septate (coenocytic) hyphae typical of a zygomycetous fungus.
Microscopy: Apophysomyces elegans showing distinctive funnel-shaped apophyses and a conspicuous pigmented sub-apical thickening below the apophysis.

Comment: Apophysomyces elegans is a rare human pathogen usually associated with invasive lesions following traumatic implantation of the fungus through the skin. It is a soil fungus with a tropical to sub-tropical distribution.
About Apophysomyces Back to virtual assessment